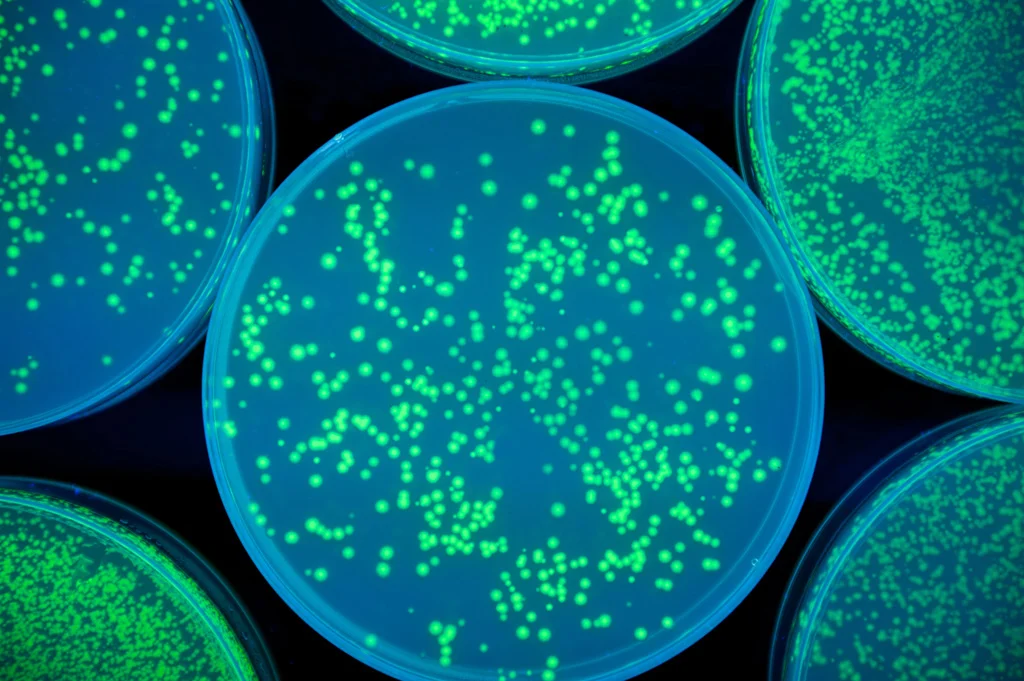

What If Your Own Body Could Fight Cancer and Win?
Imagine that you have been through these treatments: chemotherapy that left you exhausted and sick, radiation that burned both cancer and healthy tissue, and targeted drugs that worked for a while before the cancer found a way around them. Each of these came with its own challenges: nausea, hair loss, hospital visits, emotional toll. And despite it all, the cancer came back—smarter, stronger, harder to fight. You feel depressed. You lose all your hope. Then your doctor tells you about something different. Not another drug to attack the tumor directly but a therapy that helps your immune system recognize and fight the cancer itself.

Initially, it sounds too good to be true. However, you undergo the therapy. Surprisingly, it starts working! You receive an infusion—not of poison, but of precision. The therapy is designed to unblock your immune system’s natural brakes, which cancer had used to hide itself. Suddenly, your T-cells—your body’s elite defenders—can see the enemy again.
Or perhaps it is a therapy that introduces Natural Killer (NK) cells. These cells, part of your innate immune system, are known for their ability to identify and destroy tumor cells without prior sensitization. They act as a rapid response team, attacking cancer cells directly and enhancing the overall immune response.
In another scenario, the therapy might involve γδ T cells. These unique T cells recognize tumor antigens in an MHC-independent manner, allowing for broad tumor targeting. They exhibit strong cytotoxic activity and play a crucial role in shaping the tumor microenvironment, making them versatile agents in cancer immunotherapy.
Alternatively, the therapy could reprogram macrophages. These immune cells can be switched from supporting tumor growth to attacking it. By reprogramming macrophages, the therapy enhances their ability to engulf and destroy cancer cells, contributing to a more comprehensive immune response.
Each of these approaches, whether involving T-cells, NK cells, γδ T cells, or macrophages, represents a different facet of a multi-faceted assault on cancer, ensuring that your immune system is fully equipped to combat the disease from all angles.
Within weeks, your bloodwork shows changes. A scan reveals shrinking tumors. But the biggest shift is something you can’t see: your immune system is now leading the charge. And you realize: this isn’t just another treatment. It’s your own body, finally fighting back—with a memory, a strategy, and a chance at lasting control. In 1968, Dr. Steven Rosenberg, a pioneering cancer researcher, encountered a remarkable case that would shape his career and the future of cancer treatment. A patient with a large tumor in his stomach underwent surgery to remove it, but smaller growths in his liver were left untreated. During a routine follow-up operation, Dr. Rosenberg discovered that the cancer in the patient's liver had mysteriously disappeared. This unexpected outcome sparked Dr. Rosenberg's lifelong quest to understand and harness the body's immune system to fight cancer.
This led to the development of immunotherapy, a groundbreaking approach in cancer treatment. Immunotherapy helps the immune system fight cancer by boosting or modifying its natural functions to target and destroy cancer cells more effectively.
What Is Immuno-Oncology?
Immuno-oncology (IO), also known as cancer immunotherapy, is a groundbreaking area of cancer treatment that leverages one of the body’s own immune system to identify, target, and eliminate cancer cells. Unlike traditional therapies such as chemotherapy or radiation, which attack both healthy and cancerous cells directly, IO activates and strengthens the body’s natural defense mechanisms to recognize and destroy cancer with greater precision and long-term effectiveness.
Immuno-oncology is based on a simple but revolutionary idea: cancer is not invisible to the immune system; it manages well to hide itself. Tumors can manipulate certain biological pathways to suppress immune responses, essentially turning off the body’s ability to detect and fight them. IO treatments are designed to remove these "brakes" on the immune system, allowing immune cells—especially T-cells—to spring into action and attack cancer cells as they would viruses or other foreign invaders.
There are several key types of IO therapies:
- Checkpoint inhibitors block specific proteins (like PD-1, PD-L1, and CTLA-4) that cancer cells use to avoid immune detection.
- CAR-T cell therapy involves modifying a patient’s own T-cells to recognize and destroy cancer cells more effectively.
- T-cell transfer therapy: This involves enhancing the patient's own T-cells to better fight cancer.
- Cancer vaccines aim to stimulate the immune system to mount a response against specific tumor markers.
- Monoclonal antibodies and bispecific antibodies can bind to cancer cells or immune cells and enhance their interaction.
- Cytokine therapies use signaling proteins to boost the overall activity and coordination of immune responses.

These treatments can be used alone or in combination with other therapies to improve outcomes. In some cases, immuno-oncology therapies lead not just to tumor shrinkage but to long-lasting remission, even in advanced or treatment-resistant cancers.
Another unique feature of IO is its potential for immunological memory—the ability of the immune system to remember and respond more quickly to cancer cells if they return. This increases the possibility of not just managing cancer but of achieving durable control or even a functional cure in certain patients.
Immuno-oncology has already transformed the treatment landscape for cancers like melanoma, lung cancer, bladder cancer, and more. As research expands, its promise is extending to a broader range of tumors, including those that were once considered untreatable.
Connect with our scientific experts for your drug discovery, development and manufacturing needs
Immuno-Oncology Services Offered by CDMOs and CROs
With the rapid evolution of immune-based cancer treatments, Contract Development and Manufacturing Organizations (CDMOs) and Contract Research Organizations (CROs) are expanding their capabilities to meet the growing demand for predictive, scalable, and clinically relevant Immuno-Oncology (IO) services. Leading organizations such as Labcorp Drug Development, ATCC, and Creative Biolabs have developed sophisticated platforms that support every stage of IO development—from exploratory research to regulatory submission.
1. Advanced Cell Models and Functional Screening Platforms
One of the foundational components of IO services is access to high-quality cell models and assays that accurately reflect the tumor-immune microenvironment. CRDMOs now offer curated collections of validated cancer cell lines, genetically engineered immune cells (e.g., CAR-T, PD-1/PD-L1 reporter cells), and coculture systems that enable researchers to study cell-cell interactions under immune pressure.
These resources support functional assays such as T-cell activation, cytotoxicity, proliferation, and migration, enabling a comprehensive evaluation of immunomodulatory compounds. Moreover, humanized immune effector cells (e.g., NK-92, PBMCs, dendritic cells) are often incorporated into multiparametric in vitro platforms to simulate innate and adaptive immune responses. These well-characterized, reproducible models improve preclinical predictability and reduce translational gaps.
2. Complex Immuno-Oncology Assays and Mechanistic Studies
Complex immuno-oncology assays and mechanistic studies are essential for the development and evaluation of advanced cancer therapies. These assays are designed to model the intricate interactions within the tumor microenvironment (TME) and assess the efficacy and mechanisms of action of immuno-oncology drugs.
One approach involves using patient-derived organoids (PDOs), which reflect the genetic and morphological profiles of the original tumors. These organoids can be co-cultured with immune cells to reconstitute the TME, allowing researchers to study drug effects in a more physiologically relevant context. Another method uses fresh ex vivo patient tissue cultures, which maintain the native TME and provide a closer approximation to clinical scenarios.
These assays often employ advanced techniques such as high-content imaging (HCI) for phenotypic analysis, flow cytometry for cell characterization, and multiplex detection systems like Luminex and MSD for quantifying multiple immune markers simultaneously. By integrating these complex models and technologies, researchers can gain deeper insights into how immuno-oncology therapies modulate the immune system and target cancer cells effectively.
Contract Research Organizations (CROs) such as Creative Biolabs, Charles River Laboratories, WuXi AppTec, PAREXEL, and ICON plc play a crucial role in advancing bispecific and CAR T-cell therapies to clinical stages. Creative Biolabs specializes in custom CAR design and preclinical testing, offering essential services like vector construction and both in vitro and in vivo testing for early-stage development. Charles River Laboratories provides comprehensive support from preclinical research to regulatory approval, utilizing their global reach and advanced facilities to speed up development timelines. WuXi AppTec offers integrated services across the development spectrum, focusing on manufacturing and regulatory compliance, which are vital for bringing therapies to market. PAREXEL excels in clinical trial management and regulatory consulting, ensuring smooth navigation through complex regulatory environments. ICON plc supports clinical trials with robust patient recruitment, data management, and regulatory expertise, ensuring efficient and effective trial conduct.
Additional CROs contributing to the development of bispecific and CAR T-cell therapies include Labcorp Drug Development, which provides end-to-end drug development services, including biomarker discovery, clinical trial management, and regulatory support, critical for the successful development of advanced therapies. Medpace offers comprehensive clinical trial services with a focus on oncology, providing expertise in trial design, patient recruitment, and data analysis to ensure efficient progression through clinical phases.
Creative Biolabs and similar CDMOs offer customizable, mechanism-of-action-driven immunoassays that provide deeper insights into how candidate therapies affect the immune system. These include:
- T-cell killing assays using real-time imaging and flow cytometry
- Immune checkpoint blockade studies monitoring receptor-ligand interactions (e.g., PD-1/PD-L1, CTLA-4/CD80)
- Cytokine release assays assessing potential toxicity and systemic immune activation
- ADCC (Antibody-Dependent Cell Cytotoxicity) and CDC (Complement-Dependent Cytotoxicity) assays for therapeutic antibodies
- Tumor antigen presentation and immune evasion modeling
These platforms are further supported by multiplex detection systems, such as Luminex and MSD (Meso Scale Discovery), allowing parallel quantification of dozens of immune markers and soluble factors from a single sample. The assays are modular and can be adapted for monoclonal antibodies, bispecifics, CAR-T cells, vaccines, or oncolytic viruses.
3. Predictive In Vivo and Translational Models
Labcorp and other CROs provide state-of-the-art in vivo services using models specifically designed for immuno-oncology applications. These include syngeneic tumor models in immunocompetent mice that recapitulate immune-tumor dynamics, as well as humanized mouse models reconstituted with human immune systems. These models allow the evaluation of checkpoint inhibitors, immune cell engagers, or adoptive cell therapies in an environment that mimics human responses more closely than traditional xenografts.
Additionally, tumor growth inhibition, immune cell infiltration, cytokine profiles, and survival data can be monitored longitudinally. Some platforms also offer orthotopic and metastatic tumor models, which provide more realistic disease progression patterns and better insight into therapeutic efficacy and immune surveillance.
4. Immuno-Profiling, Biomarkers, and Flow Cytometry
Immuno-profiling, biomarkers, and flow cytometry are integral components of modern immuno-oncology research. Immuno-profiling involves the comprehensive analysis of immune cell populations and their functional states within a biological sample. This process helps identify specific biomarkers that can predict responses to therapies, track disease progression, and understand the underlying mechanisms of immune responses.
Flow cytometry is a powerful tool used in immuno-profiling. It allows for the simultaneous measurement of multiple parameters at the single-cell level, providing detailed insights into the phenotypic and functional characteristics of immune cells.
Biomarkers identified through flow cytometry can include surface proteins, intracellular molecules, and secreted factors that are indicative of immune cell activation, differentiation, and function. For example, a 47-marker immune profiling flow cytometry assay has been developed to enable comprehensive antigen-specific immune analysis, providing deep insights into the cell-mediated adaptive immune response. Additionally, computational tools like FlowCT facilitate the analysis of large immunophenotypic datasets, helping to uncover cellular diversity and identify biomarkers predictive of treatment outcomes.
CRDMOs now integrate deep immune profiling into every phase of IO development. Services typically include:
- Multiparameter flow cytometry to phenotype immune cells from blood, tumor, and lymphoid organs.
- Transcriptomic and proteomic analysis of immune-related gene signatures.
- Cytokine and chemokine profiling using ELISA, Luminex, or MSD platforms.
- Biomarker discovery and validation tied to mechanism of action, patient response, and safety prediction.
Several Contract Research Organizations (CROs) utilize immuno-profiling, biomarkers, and flow cytometry in their research and development processes. Explicyte Immuno-Oncology offers extensive flow cytometry services for immuno-oncology, including multiplexed immunophenotyping and anti-tumor immune response profiling. They use advanced flow cytometers like the Agilent NovoCyte Quanteon, capable of quantifying up to 17 parameters, to track the efficacy and mechanisms of action of cancer immunotherapies. Precision for Medicine specializes in biomarker development and validation, including immune monitoring biomarkers through flow cytometry. They focus on liquid biopsy-based biomarkers (ctDNA or CTC), solid tumor biomarkers (IHC, multiplex immunofluorescence), and epigenetic cell phenotyping. These CROs leverage sophisticated technologies and methodologies to advance the understanding and development of immuno-oncology therapies.
5. Manufacturing and Preclinical Development Integration
In addition to discovery and preclinical testing, CDMOs such as Creative Biolabs also provide bioproduction and analytical development services, allowing seamless transition of validated candidates into clinical-grade formats. These services include recombinant antibody and cell therapy production under GMP conditions, stability studies, quality control, and regulatory documentation. For immune cell therapies, CDMOs offer lentiviral vector design, gene editing services, and expansion protocols that are scalable for early-phase trials.
6. Regulatory Guidance and IND-Enabling Studies
Finally, IO-focused CDMOs help sponsors prepare IND-enabling studies, integrating immune safety data, pharmacokinetic/pharmacodynamic (PK/PD) correlations, and mechanism-based toxicology reports. These services are especially important for novel modalities like T-cell engagers and bispecific antibodies, which require careful monitoring of immune-related adverse events such as cytokine release syndrome. The integrated nature of services—ranging from mechanistic assays to CMC and regulatory support—helps clients de-risk their pipeline and meet evolving FDA and EMA requirements.
The modern landscape of immuno-oncology demands more than isolated assays—it requires an integrated, translational platform that reflects clinical complexity. CDMOs like Labcorp, ATCC, and Creative Biolabs offer such platforms, merging cutting-edge biology with regulatory expertise and scalable manufacturing. Whether it’s a monoclonal antibody, a bispecific T-cell engager, or a next-generation CAR-T therapy, these partners help bring immuno-oncology innovations from the lab bench to the clinic with greater speed, precision, and confidence.
Aurigene's Offerings
At Aurigene Pharmaceutical Services, we offer comprehensive immuno-oncology solutions that support every stage of discovery and preclinical development. Our infrastructure, scientific expertise, and customizable services are designed to empower your research in immunotherapies, ADCs, bispecifics, and more.
Our state-of-the-art infrastructure enables high-quality, reproducible, and efficient research outputs:
- Advanced flow cytometers like the BD Symphony and Beckman Cytoflex, capable of quantifying up to 18 parameters, to track the efficacy and mechanisms of action of cancer immunotherapies.Dedicated immuno-oncology labs with modular spaces for cellular and biochemical assay workflowsAdvanced imaging and detection platforms for real-time cytotoxicity, phagocytosis, and internalization studies using Incucyte®,
- Specialized equipment for multiplexed immunophenotyping , cytokine quantification, and surface marker analysis
- Capability to generate custom reagents, such as tagged antibodies and recombinant proteins, kock-in and knock-out cell lines, mRNA LNPs
We offer a broad range of customized in vitro assay services, enabling targeted, mechanism-of-action-driven evaluations for diverse immunotherapy modalities:
Biochemical Assays
- Antigen-antibody binding assays (protein-based ELISA)
- Cell-based FACS binding studies
- Signal transduction assays, including phospho-flow, western blotting for phosphorylation, and phospho-ELISA
- Enzyme activity assessments across multiple platforms
Cellular Assays
- T-cell activation via anti-CD3/CD28 stimulation (plate-bound, soluble, or bead-based formats)
- Tumor-dependent immune activation assays using bispecific antibodies (e.g., binding, cytotoxicity)
- Fc-dependent assays including ADCC, ADCP, and CDC using FACS and Incucyte®
- Fc-independent killing assays (CD3xTAA BsAb-based, T cell- or NK-mediated killing, CAR-T, MLR)
- Cytotoxicity assays using FACS, Incucyte®, CellTiter-Glo®, and MTT
- Cell cycle profiling
- Macrophage differentiation and polarization (M1/M2)
- Antibody internalization (FACS-based direct and pHrodo®-based detection)
- Surface marker and target expression profiling
- Cytokine profiling by FACS, ELISA, and qRT-PCR
- In vitro Treg expansion and T-cell suppression assays
Our strengths lie in the unique combination of expertise, flexibility, and collaborative partnership:
- Deep expertise in immuno-oncology and biologics, including ADCs and bispecific antibodies
- Experienced, multidisciplinary scientific team with backgrounds in immunology, oncology, and cell biology
- Customized study designs and rapid assay development, tailored to your molecule’s mechanism of action
- Flexible engagement models, from target validation to IND-enabling studies
- End-to-end in vitro solutions delivered under one roof, ensuring faster turnaround and seamless integration
- Commitment to innovation and speed, with agile execution tailored to your development timelines
Discover how our cutting-edge immuno-oncology solutions can accelerate your research—download the Immuno-oncology Services Flyer now.
Delve into our comprehensive white paper, Immuno-Oncology: Therapies and Challenges, which explores emerging modalities such as bispecific antibodies, adoptive T-cell therapies, and cancer vaccines, and addresses the complexities of translating these innovations into effective clinical solutions.
Future Direction of the Field of Immuno-Oncology
The future of IO is rapidly evolving, moving from a single-class success story to a multifaceted therapeutic revolution. Building on the foundations laid by checkpoint inhibitors and CAR-T cell therapies, IO is entering a new phase, defined by smarter targets, more complex biology, and more personalized interventions. The next wave of IO innovation is being shaped by deep mechanistic insights, translational technologies, and an urgent focus on expanding efficacy across cancer types and patient populations.
Diversifying Immune Targets and Escaping Resistance
A major frontier in IO is the development of therapies targeting novel immune checkpoints and co-stimulatory molecules beyond PD-1, PD-L1, and CTLA-4. The targets such as LAG-3, TIGIT, TIM-3, and CD47 are showing promise, especially in patients with resistance to first-generation therapies. These pathways are being explored in both monotherapy and rational combinations, with growing attention to dual checkpoint blockade and checkpoint plus co-stimulatory agonist pairings like PD-1/4-1BB.
The future will also witness better control of immune activation. Rather than unleashing the immune system indiscriminately, next-gen IO agents aim to fine-tune the immune response, avoiding autoimmunity and cytokine release syndrome. Multi-specific formats (e.g., tri-specific antibodies) are already being explored for modular immune engagement, adapting to the tumor’s immune escape tactics in real time.
Reprogramming the Tumor Microenvironment (TME)
While existing IO drugs succeed in "hot" tumors with pre-existing immune activity, many tumors remain immunologically "cold" due to suppressive microenvironments. Researchers are now focused on TME normalization, turning non-responsive tumors into fertile ground for immune attack. Strategies include depleting suppressive myeloid cells (e.g., MDSCs), re-educating tumor-associated macrophages (TAMs), inhibiting stromal barriers, and altering metabolic pathways that limit T-cell function.
Targeted delivery of cytokines, toll-like receptor agonists, and oncolytic viruses into the TME is showing potential in boosting local immune reactivity without systemic toxicity. Some researchers emphasize that understanding tumor-immune crosstalk using spatial and single-cell technologies will help tailor microenvironment-focused IO approaches.
Advancing Cellular and Engineered Immune Therapies
CAR-T cell therapy marked a turning point for hematologic malignancies. However, the next frontier lies in adapting these therapies to solid tumors. Key challenges include improving tumor homing, overcoming immunosuppression, and managing toxicity. To address these, researchers are developing multi-antigen CARs, logic-gated CARs, armored CARs that secrete cytokines, and switchable CARs that can be modulated in vivo for safety.
To overcome challenges associated with systemic CAR-T cell therapies, researchers are developing localized delivery methods. These include hydrogel-based systems, microneedle patches, and thin-film implants designed to release CAR-T cells directly into the tumor microenvironment. Such approaches aim to enhance the efficacy of CAR-T cells against solid tumors while minimizing systemic side effects.
Beyond CAR-T, TCR-T, CAR-NK, and γδ T cell therapies are emerging as promising platforms. Engineered innate cells like NKs and macrophages may offer shorter manufacturing times, lower risk of cytokine storm, and broader tumor targeting.
Moreover, allogeneic “off-the-shelf” cell therapies using gene editing (CRISPR, TALEN) and immune cloaking strategies are poised to increase accessibility and scalability of cell-based IO, making them less personalized but more practical for wider patient pools.
Personalized Neoantigen Vaccines and mRNA Platforms
Cancer vaccines are undergoing a renaissance. The success of mRNA technology in COVID-19 has accelerated its application to oncology. Today, personalized neoantigen vaccines, designed from a patient's tumor-specific mutations, are being rapidly developed using genomic sequencing and AI-powered epitope prediction tools.

Companies are already combining mRNA vaccines with checkpoint inhibitors in early trials, and results are encouraging—especially in melanoma, pancreatic, and lung cancers. Future platforms will offer on-demand cancer vaccine design, produced within days of biopsy, and potentially integrated with circulating tumor DNA (ctDNA) monitoring for real-time updates.
The concept of digital twins—virtual replicas of patients—allows for simulation of disease progression and treatment responses. In immuno-oncology, digital twins can help in understanding individual tumor behaviors and optimizing therapeutic strategies before actual clinical application.
Data-Driven Immune Profiling and AI Integration
One of the most transformative developments in IO is the shift toward integrated immune profiling and artificial intelligence (AI). Traditional biomarkers like PD-L1 and TMB are giving way to multidimensional predictors incorporating transcriptomics, proteomics, spatial biology, and machine learning algorithms.

AI can now analyze massive patient datasets to uncover unseen response patterns, optimize combination regimens, and predict immune-related adverse events. In the future, dynamic, adaptive treatment models will become possible—where therapy evolves with the tumor's immune landscape, monitored by liquid biopsies, real-time imaging, and digital pathology.
Next-Gen Formats and Combination Therapeutics
The IO pipeline is rapidly diversifying into bispecific antibodies, trispecifics, antibody-drug conjugates (ADCs) with immune payloads, and small molecules with immune-modulating properties. These formats offer combinatorial advantages in a single molecule, such as dual targeting of tumor and immune cells or combining immune activation with direct tumor killing.
Molecular MRI is emerging as a non-invasive method to monitor the effectiveness of immunotherapies. By providing detailed images of tumor biology, this technique can help in early detection of treatment responses or resistance, facilitating timely adjustments in therapy.
Innovative research is exploring the use of engineered bacteria to deliver therapeutic agents directly to tumors. These bacteria can be programmed to produce anti-cancer compounds within the tumor microenvironment, offering a novel approach to cancer treatment.
Also on the horizon are combinations with non-immunotherapies—such as epigenetic modifiers, radiotherapy, anti-angiogenics, and targeted kinase inhibitors—to open immune access and sensitize tumors to immunotherapy. These are not “one-size-fits-all” regimens but precision-guided combinations, informed by a tumor’s unique biology and immune status.
Towards Prevention, Early Intervention, and Global Equity
The most visionary direction in IO is its potential to prevent cancer altogether. With deeper understanding of immune surveillance, some researchers foresee immune-modulating agents used in high-risk individuals to prevent tumor development or recurrence. Adjuvant and neoadjuvant immunotherapy trials are already underway to intercept cancer at its earliest, most treatable stages.
Equally important is the global expansion of IO access. Cost, cold-chain requirements, and complex manufacturing currently limit availability to select regions. Future efforts will include decentralized production of off-the-shelf therapies, simplified dosing schedules, and inclusion of diverse patient populations in global clinical trials.
SA Personalized, Precise, and Immune-Intelligent Future
Immuno-oncology is no longer a niche field—it’s a central pillar of modern cancer therapy. The future lies in layered innovation, combining new targets, engineered cells, AI-guided strategies, and personalized vaccines into cohesive, adaptive treatment plans. The ultimate goal is not only to extend survival—but to achieve durable, relapse-free control and even cancer prevention. As science continues to uncover the immune system’s hidden potential, immuno-oncology is poised to become a defining force in the future of medicine.
